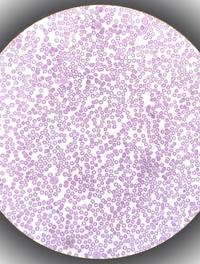

Chez le sujet âgé aussi la réduction du LDL-C diminue les événements CV

En prévention primaire, les grands essais cliniques qui ont inclus une majorité de sujets âgés de moins de 70 ans, ont montré de façon [...]

En prévention primaire, les grands essais cliniques qui ont inclus une majorité de sujets âgés de moins de 70 ans, ont montré de façon [...]

Le cancer de la prostate est à l’origine d’une lourde morbi-mortalité qui affecte la population masculine à un échelon mondial. Sa [...]

L’hidradénite suppurée ou maladie de Verneuil est une maladie inflammatoire chronique récidivante qui se traduit par des nodules cutanés [...]

L’examen des patients asthmatiques se déroule traditionnellement en face-à-face, la fonction pulmonaire étant mesurée sur place. Cependant, [...]

Les inhibiteurs de la pompe à protons (IPP) sont très utilisés en pédiatrie dans les pathologies œsogastriques, telles que le reflux [...]

L’infertilité est le lot d’un couple sur six environ dans le monde. Plus d’une fois sur deux, c’est l’homme qui est en cause, du fait [...]

Dans un important éditorial, Price et coll. abordent le rôle de l'activité physique dans la gestion de l'asthme (1). Il s'agit d'un [...]

Le rétrécissement aortique calcifié (RAC) sévère qui est actuellement la plus fréquente des valvulopathies de l’adulte, est couramment [...]

Une sinusite aiguë est fréquemment traitée par une antibiothérapie en l’absence d’étiologie connue. La raison est la crainte de complications [...]

En 2018, selon Santé Publique France, le cancer responsable du plus grand nombre de décès était chez l’homme le cancer bronchique essentiellement [...]

Les symptômes du bas appareil urinaire (LUTS) chez l’homme sont fréquents et augmentent avec l’âge. Il peut s’agir de faible débit [...]

Une méta-analyse révèle que la transplantation de microbiote intestinal (TMI), également communément appelée transplantation de microbiote [...]

Les anticorps monoclonaux ciblant l'amyloïde-bêta (Aβ) ont démontré leur potentiel pour ralentir le déclin cognitif et fonctionnel [...]

La coloration noire de la thyroïde a été décrite en 1976 chez un homme prenant de la minocycline (MNC) depuis un an. A ce jour, environ [...]

Trente à 40 % des patients âgés vulnérables atteints d’une fibrillation auriculaire (FA) reçoivent des antivitamines K (AVK) plutôt [...]
Le purpura thrombopénique auto-immun chronique (PTI) est caractérisé par la destruction prématurée des plaquettes recouvertes d'auto-anticorps, [...]

La cytoréduction chirurgicale vise à réduire la quantité de cellules cancéreuses dans la cavité abdominale chez les patients atteints [...]

Les orthèses plantaires (OP) sont couramment utilisées dans le traitement des blessures du pied, de la cheville et des membres inférieurs, [...]

Dans le but d'élucider davantage les facteurs environnementaux qui sont au cœur de la compréhension de l'asthme, la revue PAI (Pediatric [...]

Un nouveau-né sur 2 de mère diabétique de type 1 présente des complications, principalement un accouchement prématuré, une macrosomie [...]

Les méningites bactériennes aiguës dites spontanées sont plus fréquentes aux âges extrêmes de la vie. Elles s’associent volontiers [...]

La fièvre hémorragique de Crimée-Congo (CCHF) est une zoonose transmise par des tiques. Les tableaux cliniques sont très variés, allant [...]

Dans le VIH/sida, la non-adhérence au ART est synonyme de rebond virologique et d’apparition de résistances. Les piluliers ou la parole [...]

Les effets nocifs pour la santé de la consommation de cannabis sont avérés. L’Académie Nationale de Médecine a récemment confirmé son [...]

Une inhalation méconiale (IM) est une détresse respiratoire néonatale secondaire au passage de liquide amniotique teinté par du méconium [...]

La présentation de l’asthme bronchique est variable sur le plan clinique mais aussi sur celui des mécanismes physiopathologiques en [...]

La pandémie de COVID-19 a eu un profond impact. Alors que les sociétés entrent dans une phase post-pandémique, il est essentiel d'évaluer [...]

Pour les personnes non vaccinées, le risque de zona au cours de la vie est d’environ 30 %. Selon une étude états-unienne, son incidence [...]

Les corticostéroïdes inhalés (CSI) réduiraient le risque d'exacerbations des BPCO sévères. Toutefois, leur utilité est discutée. Les [...]

L’épaisseur du cortex cérébral, désormais mesurable en neuro-imagerie, constitue un biomarqueur macroscopique corrélé à l’intégrité [...]